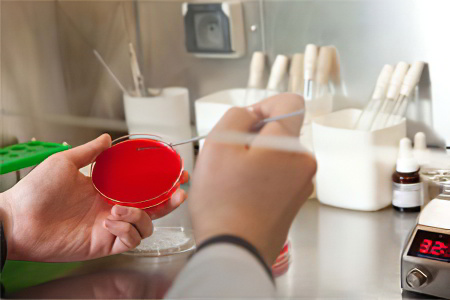

Скрытая кровь в кале – что это значит?
Небольшое количество крови может нормально присутствовать в кале — не более 2 мг гемоглобина на 1 г фекалий. При такой концентрации здоровый человек может терять до 2 мл крови в сутки с испражнениями. Однако, если кровотечение усиливается, цвет каловых масс изменяется, и оттенок может указать на источник проблемы. Чем темнее кал, тем выше расположена проблема. Например, при язве желудка или двенадцатиперстной кишки кал становится черным и дегтеобразным (мелена). Если причина — обострение язвенного энтероколита, испражнения будут бордовыми. Кровоточащие полипы, геморроидальные узлы и злокачественные опухоли в прямой кишке могут привести к появлению ярко-красных прожилок и пятен на кале. Эти симптомы требуют немедленного обращения к врачу.
[Видео] Врач-колопроктолог Ильсур Мансурович Фатхутдинов — что делать, если обнаружена скрытая кровь в кале:
Скрытая кровь в кале — это кровь, которую невозможно выявить ни визуально, ни при микроскопическом анализе испражнений. Обнаружить её можно только с помощью анализа на скрытую кровь. Положительный результат указывает на наличие скрытого желудочно-кишечного кровотечения и требует дальнейшего обследования пациента.
Анализ кала на скрытую кровь является важным диагностическим инструментом, который позволяет выявить наличие кровотечений в желудочно-кишечном тракте. Врачи отмечают, что этот тест может помочь в ранней диагностике различных заболеваний, включая язвы, полипы и рак кишечника. Поскольку скрытая кровь может быть признаком серьезных патологий, важно проводить этот анализ регулярно, особенно для людей старше 50 лет или тех, кто имеет предрасположенность к заболеваниям ЖКТ.
Специалисты подчеркивают, что результаты анализа могут быть ложноположительными или ложноотрицательными, поэтому для точной диагностики часто требуется дополнительное обследование. Врачи рекомендуют не игнорировать результаты теста и обсуждать их с медицинским специалистом, чтобы определить дальнейшие шаги и необходимость дополнительных исследований. Таким образом, анализ кала на скрытую кровь играет ключевую роль в профилактике и раннем выявлении заболеваний, что может существенно повысить шансы на успешное лечение.

Кому показан анализ кала на скрытую кровь?
Исследование данного типа назначается в следующих случаях:
- Постоянные или периодические боли в животе, а также в правом или левом подреберье.
- Дискомфорт и болезненные ощущения во время или после дефекации.
- Чувство наличия инородного тела в прямой кишке.
- Нарушения стула: запоры, поносы, аномальные изменения объема каловых масс, их цвет, консистенция или запах, наличие подозрительных включений (пена, слизь, кровь, гной, паразиты или их яйца).
- Потеря аппетита и резкое снижение веса без очевидных причин.
- Тошнота, рвота, отрыжка, изжога, неприятный привкус во рту.
- Необъяснимое повышение температуры тела.
- Установленные заболевания ЖКТ: болезнь Крона, полипоз кишечника, неспецифический язвенный колит, дивертикулез, варикоз пищевода, гельминтоз и другие. Исследование проводится для определения стадии болезни или контроля лечения.
- Вызывающие беспокойство результаты предыдущих обследований, таких как копрограмма, общий или биохимический анализ крови.
- Профилактика рака кишечника у людей старше 40-50 лет, особенно при наличии неблагоприятной наследственности.
| Результат анализа кала на скрытую кровь | Возможные причины положительного результата | Дополнительные исследования, которые могут потребоваться |
|---|---|---|
| Положительный результат (обнаружена скрытая кровь) | Язвенная болезнь желудка и двенадцатиперстной кишки, полипы, рак желудочно-кишечного тракта, дивертикулез, воспалительные заболевания кишечника (болезнь Крона, язвенный колит), геморрой, анальные трещины, травмы желудочно-кишечного тракта, прием некоторых лекарственных препаратов (например, аспирин, НПВС) | Колоноскопия, гастроскопия, исследование на наличие Helicobacter pylori, биопсия, дополнительные анализы крови (например, общий анализ крови, биохимический анализ крови) |
| Отрицательный результат (скрытая кровь не обнаружена) | Отсутствие патологии желудочно-кишечного тракта | В зависимости от клинической картины, дополнительные исследования могут не потребоваться. |
| Ложноположительный результат | Прием некоторых продуктов питания (например, красное мясо, свекла), менструации у женщин, некоторые лекарственные препараты | Повторный анализ после исключения влияющих факторов |
Подготовка, диета, сбор и сдача анализа
Проведение исследования на наличие скрытой крови в кале оправдано только при строгом соблюдении всех правил подготовки. В противном случае вероятность получения неверного результата значительно возрастает.
Рассмотрим все шаги по порядку:
- Отложите анализ до устранения следующих факторов: стоматит, пародонтоз, носовое кровотечение, менструация, диспепсия, гематурия, обострение геморроя, недавние диагностические процедуры на кишечнике (колоноскопия, ректороманоскопия) и половой акт через задний проход. Эти обстоятельства могут существенно исказить результаты исследования, поэтому важно либо решить возникшую проблему, либо подождать несколько дней, в зависимости от ситуации.
- За неделю до анализа рекомендуется прекратить прием любых медикаментов, которые могут повлиять на состав кала. Это касается НПВП (аспирина, ибупрофена, напроксена), барбитуратов, антикоагулянтов, средств, стимулирующих кишечную перистальтику, аскорбиновой кислоты, а также препаратов и биологически активных добавок, содержащих железо. Если вы регулярно принимаете какие-либо лекарства и не уверены в их влиянии на результаты, лучше проконсультироваться с врачом.
- За три дня до анализа следует соблюдать специальную диету. Исследование на скрытую кровь обычно проводится с использованием лабораторных проб, чувствительных к пище, которую употребляет пациент. Поэтому временно исключите мясо, птицу, рыбу и субпродукты, так как они могут содержать кровь, не относящуюся к вам. Также рекомендуется избегать некоторых бобовых, овощей, фруктов и ягод, богатых железом и витамином C или сильно влияющих на перистальтику кишечника, таких как яблоки, сельдерей, клюква, апельсины, шпинат, орехи, капуста, томаты, морковь, свекла, фасоль, соя и чечевица.
- За 12 часов до анализа следует отказаться от использования зубной щетки и от жесткой пищи, которая может повредить десны и привести к попаданию крови изо рта в пищеварительный тракт.
Успешная сдача анализа на скрытую кровь = подготовка + диета, запомните это!
Анализ кала на скрытую кровь — это важное диагностическое исследование, которое помогает выявить наличие крови в кале, что может быть признаком различных заболеваний. Многие люди отмечают, что этот тест является простым и безболезненным способом проверки состояния здоровья. Он может помочь в ранней диагностике таких серьезных заболеваний, как рак толстой кишки, язвы или воспалительные процессы в кишечнике.
Пациенты часто делятся своим опытом, подчеркивая, что анализ позволяет получить ценную информацию о состоянии пищеварительной системы. Некоторые отмечают, что результаты могут быть неожиданными, и важно не игнорировать дальнейшие обследования, если тест показывает положительный результат. В целом, анализ кала на скрытую кровь воспринимается как полезный инструмент для профилактики и раннего выявления заболеваний, что способствует более эффективному лечению и улучшению качества жизни.

Как правильно собрать и сдать кал?
Подготовительный этап завершен, и теперь необходимо собрать материалы для исследования и отправить их в лабораторию:
- Утром, до завтрака, проведите гигиеническую процедуру интимной зоны с обычным мылом. Тщательно ополосните и высушите.
- Сделайте дефекацию в заранее подготовленную чистую емкость. Процесс должен проходить естественно, без использования клизм или слабительных средств. Образец кала нельзя брать из унитаза. Для анализа кала на скрытую кровь у ребенка образец берется из хорошо вымытого горшка, с пеленки или клеенки.
- Для сбора и транспортировки биоматериала лучше использовать специальные стерильные контейнеры с крышкой и ложечкой, которые можно приобрести в аптеке. Если таких контейнеров нет, подойдет маленькая стеклянная баночка, предварительно продезинфицированная. Наберите небольшое количество кала из разных участков испражнений, чтобы исследование было максимально информативным. В целом, достаточно объема, равного примерно 2-3 чайным ложкам.
- Лучше всего сразу доставить емкость с образцом в лабораторию. Однако допустимо хранение материала в холодильнике не более 12 часов. Это особенно удобно для маленьких детей, у которых стул может быть непредсказуемым, или для людей, которые привыкли опорожнять кишечник перед сном.
Методы проведения исследования: плюсы и минусы
В настоящее время существует четыре основных метода для выявления скрытой крови в кале:
- Реакция Грегерсена (бензидиновая проба);
- Реакция Вебера (гваяковая проба);
- Иммунохимический анализ кала;
- Флуоресцентный тест.
Рассмотрим каждую из этих методик, а также их плюсы и минусы. В России чаще всего применяются бензидиновая проба и иммунохимический анализ. Но действительно ли они являются самыми точными?

Реакция Грегерсена (бензидиновая проба)
Бензидиновая проба — это быстрый и простой лабораторный тест, который позволяет выявить кровь не только в кале, но и в других биологических жидкостях, таких как моча или рвотные массы. Тест основан на окислении бензидина (парадиаминодифенила) с использованием перекиси водорода или бария в присутствии гемоглобина. Существует несколько модификаций бензидиновой пробы, наиболее известная из которых была разработана врачом М. Грегерсеном и названа в его честь.
Метод заключается в следующем: берут 0,025 г бензидина, добавляют 0,1 г перекиси бария и 5 мл 50% раствора уксусной кислоты, тщательно перемешивают до полного растворения. Затем наносят несколько капель полученного раствора на предметное стекло с тонким слоем исследуемого кала и наблюдают за реакцией. Если в образце присутствует скрытая кровь, появляется яркое сине-зелёное окрашивание. Альтернативный вариант — приготовить насыщенный раствор бензидина в уксусной кислоте и смешать его с 3% раствором перекиси водорода в равных пропорциях. Результат будет аналогичным, а стоимость исследования останется практически неизменной.
Преимущества:
- Исключительно высокая чувствительность — 1:100 000;
- Быстрое получение результата — почти мгновенно;
- Доступность в любой лаборатории;
- Низкая стоимость.
Недостатки:
- Необходимость тщательной подготовки к сдаче анализа кала на скрытую кровь по методу Грегерсена, так как проба может давать положительный результат на животный гемоглобин, содержащийся в пище.
Реакция Вебера (гваяковая проба)
Кроме упомянутых названий, данный метод диагностики известен также как проба Ван-Деена, Альмена-Ван-Деена и гемоккульт-тест. Использование гваяковой смолы стало первой в истории медицины методикой для выявления скрытой крови в кале и других биологических жидкостях человека. Доктор Ван Деен предложил этот метод в 1864 году, и он по-прежнему активно применяется в различных странах.
Основная идея гваяковой пробы заключается в следующем: берут 3-5 граммов образца кала, растворяют его в уксусной кислоте, что приводит к выделению эфирного экстракта. Затем к этому экстракту добавляют перекись водорода и настойку гваяковой смолы, после чего наблюдают за изменениями цвета реактивов в пробирке. Если смесь становится синей, это указывает на положительный результат анализа на скрытую кровь в кале. Процедура повторяется шесть раз: анализируются два образца биоматериала, собранные в течение трех дней.
Преимущества:
- Быстрота выполнения.
- Низкая стоимость.
Недостатки:
- Низкая чувствительность: положительная реакция наблюдается только при кровопотере объемом от 30 мл и более. Колоректальный рак выявляется лишь в одной трети случаев, а доброкачественные опухоли кишечника – только в 15% случаев.
- Строгие требования к диете перед проведением анализа на скрытую кровь: гваяковая проба чувствительна не только к пероксидазе гемоглобина человека, но и к пероксидазам других гемов, содержащихся в пище.
Иммунохимический анализ кала
Данный анализ также известен как иммунологический или иммунохроматографический тест. Основой этой методики является реакция, возникающая при взаимодействии специфических антител с гемоглобином, содержащимся в человеческой крови. Ошибки в результатах исключены, так как антитела не реагируют на гемоглобин животных или железо, присутствующее в некоторых растительных продуктах. Иммунохимический анализ кала на скрытую кровь стал доступен медикам относительно недавно, но уже занял важное место в их практике.
Принцип работы метода заключается в следующем: образец кала помещается на тест-полоску или в специальное окошко планшета с реактивами – моноклональными антителами. Если в образце присутствует человеческий гемоглобин, он связывается с антителами, и в контрольной зоне появляется полоса ярко-розового или фиолетового цвета. Вторая полоса появляется всегда – она служит индикатором корректной работы прибора. Процедура сдачи анализа кала на скрытую кровь напоминает тест на беременность: все происходит быстро, просто и понятно.
В аптеке можно приобрести «ИммуноХРОМ-ГЕМ-Экспресс» или аналогичные устройства для самостоятельной диагностики скрытых желудочно-кишечных кровотечений в домашних условиях. Однако для получения надежных результатов рекомендуется провести анализ не менее трех раз с интервалами в несколько дней.
Преимущества:
- Быстрота и удобство использования;
- Нет необходимости в предварительной подготовке и соблюдении диеты;
- Высокая точность – выявляет ранние стадии колоректального рака в 97% случаев.
Недостатки:
- Относительно высокая стоимость;
- Не всегда доступен в каждой лаборатории;
- Объективность результатов анализа кала на скрытую кровь сохраняется только при кровотечении в нижних отделах пищеварительного тракта. Агрессивные ферменты, действующие на гемоглобин в желудке и тонком кишечнике, изменяют его состояние, что делает невозможным взаимодействие с моноклональными антителами.
Флуоресцентный тест
Для более полного понимания стоит отметить, что скрытую кровь можно выявить в кале с помощью химической реакции, использующей специальные реагенты. Азотсодержащие пигменты порфирины, находящиеся в молекулах гемоглобина и высвобождающиеся при их разрушении, обладают высоким коэффициентом светопоглощения, достигающим примерно 10 в 6 степени. Лаборант может зафиксировать яркое флуоресцентное свечение, если в образце кала присутствует скрытая кровь. Однако в России этот метод диагностики не получил широкой популярности, особенно по сравнению с бензидиновой пробой.
Преимущества:
- Быстрота проведения анализа;
- Низкая стоимость;
- Высокая точность — около 80%.
Недостатки:
- Необходимость соблюдения специальной диеты, так как порфирины содержатся в любом гемоглобине, включая животный.
Расшифровка результатов анализа на скрытую кровь
В зависимости от метода тестирования и внутренних процедур лаборатории результаты будут доступны в течение 1-6 дней. Методы исследования не позволяют получить точные числовые значения. В бензидиновой и гваяковой пробах реагент либо окрашивается, либо нет; различия заключаются в скорости и интенсивности окраски. Иммуноферментные и флуоресцентные тесты также имеют четкие результаты: вторая полоска либо появляется, либо отсутствует, как и свечение – оно либо присутствует, либо нет.
Для наглядности рассмотрим интерпретацию результатов анализа кала на скрытую кровь по методу Грегерсена (бензидиновая проба):
| Значение | Интерпретация |
| — | реакция отсутствует |
| + | слабо выраженная реакция |
| ++ | средне выраженная реакция |
| +++ | ярко выраженная реакция |
| ++++ | очень интенсивная реакция |
Важно: даже незначительная реакция вызывает беспокойство у врача и может привести к повторному тестированию или добавлению дополнительных методов диагностики, так как наличие скрытой крови в кале является признаком серьезных проблем со здоровьем.
Ложные результаты
Теперь давайте рассмотрим, почему результаты исследования могут быть неточными:
-
Ложноотрицательный результат анализа кала на скрытую кровь чаще всего возникает из-за нарушения методики теста или низкого качества реактивов. Также возможно, что пациент предоставил недостаточное количество биоматериала или не собрал его из разных участков каловых масс. При некоторых заболеваниях органов желудочно-кишечного тракта, таких как полипоз толстого кишечника, кровотечения могут происходить не постоянно, а лишь в определённые моменты. Поэтому рекомендуется повторять исследование несколько раз, особенно при серьёзных подозрениях на наличие болезни.
-
Ложноположительный результат анализа на скрытую кровь чаще всего связан с несоблюдением правил подготовки к тесту. Пациент мог не придерживаться рекомендованной врачом диеты, принимать лекарства, искажающие результаты, или получить травму, в результате которой кровь попала в желудочно-кишечный тракт. У грудных детей положительный результат анализа может быть ложным, если соски кормящей матери трескаются и кровоточат. В этом случае малыш может заглатывать кровь во время кормления, и она окажется в его испражнениях. Решить эту проблему с помощью сцеживания не получится, так как кровь может попасть и в грудное молоко. Лучше всего на три дня перевести младенца на искусственное вскармливание, чтобы обеспечить достоверность теста.
Положительный результат – что делать?
Пациентов с положительным результатом анализа кала на скрытую кровь часто беспокоит вопрос: что это может означать? Прежде всего, не стоит паниковать. Вероятность ошибок в анализе высока, особенно если не соблюдены правила подготовки. Рекомендуется повторить исследование как минимум трижды, прежде чем делать окончательные выводы.
Если результат оказался верным, он, скорее всего, указывает на распространенные заболевания:
- Геморрой или трещина ануса;
- Полипы, поликистоз или дивертикулез кишечника;
- Неспецифический язвенный колит;
- Язвы желудка или двенадцатиперстной кишки;
- Паразитарные инфекции;
- Варикозное расширение вен пищевода.
Все эти состояния неприятны и могут быть опасны, но наибольшее беспокойство вызывает возможность рака. Для прояснения ситуации необходимо провести дополнительные диагностические процедуры: УЗИ органов брюшной полости, рентгеноконтрастную томографию, колоноскопию и ректороманоскопию.
Это особенно важно для пациентов старше 40 лет и для тех, у кого есть близкие родственники с раком. Ранняя диагностика злокачественных опухолей кишечника может увеличить шансы на выживание в среднем на 30%. Иммунохимический анализ позволяет выявить первую стадию колоректального рака более чем в 90% случаев, а аденоматозные полипы размером более 1 см – в 60% случаев. Поэтому крайне важно не игнорировать ежегодные профилактические обследования и следовать рекомендациям врача. Заботьтесь о своем здоровье!
Вопрос-ответ
Какие болезни показывает кал на скрытую кровь?
Язвенная патология желудка или двенадцатиперстной кишки, аутоиммунные процессы кишечника – неспецифическое язвенное воспаление толстой кишки и болезнь Крона, одиночные или множественные полипы, туберкулезное поражение кишечника (энтерит или колит).
Что означает положительный анализ кала на скрытую кровь?
Положительная реакция кала на скрытую кровь означает, что у человека имеются болезни желудочно-кишечного тракта, вызывающие нарушение целостности слизистой, когда в просвет желудка или кишки выделяется небольшое количество крови.
Что должен показать тест на скрытую кровь?
Тест на скрытую кровь – один из методов исследования, способных обнаружить бессимптомное кровотечение в желудке и кишечнике. Такие кровотечения являются ранним клиническим признаком многих серьезных болезней пищеварительного тракта, включая онкологические.
Советы
СОВЕТ №1
Перед сдачей анализа кала на скрытую кровь, проконсультируйтесь с врачом о том, какие продукты и лекарства могут повлиять на результаты. Избегайте употребления мяса, некоторых овощей и витаминов, содержащих железо, за несколько дней до теста.
СОВЕТ №2
Соблюдайте правила сбора образца кала. Используйте чистую и сухую емкость, чтобы избежать загрязнения, и следуйте инструкциям по сбору, чтобы результаты были максимально точными.
СОВЕТ №3
Не забывайте, что положительный результат анализа не всегда означает наличие серьезного заболевания. Обсудите результаты с врачом, который сможет назначить дополнительные исследования для уточнения диагноза.
СОВЕТ №4
Регулярно проходите профилактические обследования, особенно если у вас есть факторы риска, такие как семейная история заболеваний кишечника. Раннее выявление проблем может значительно повысить шансы на успешное лечение.